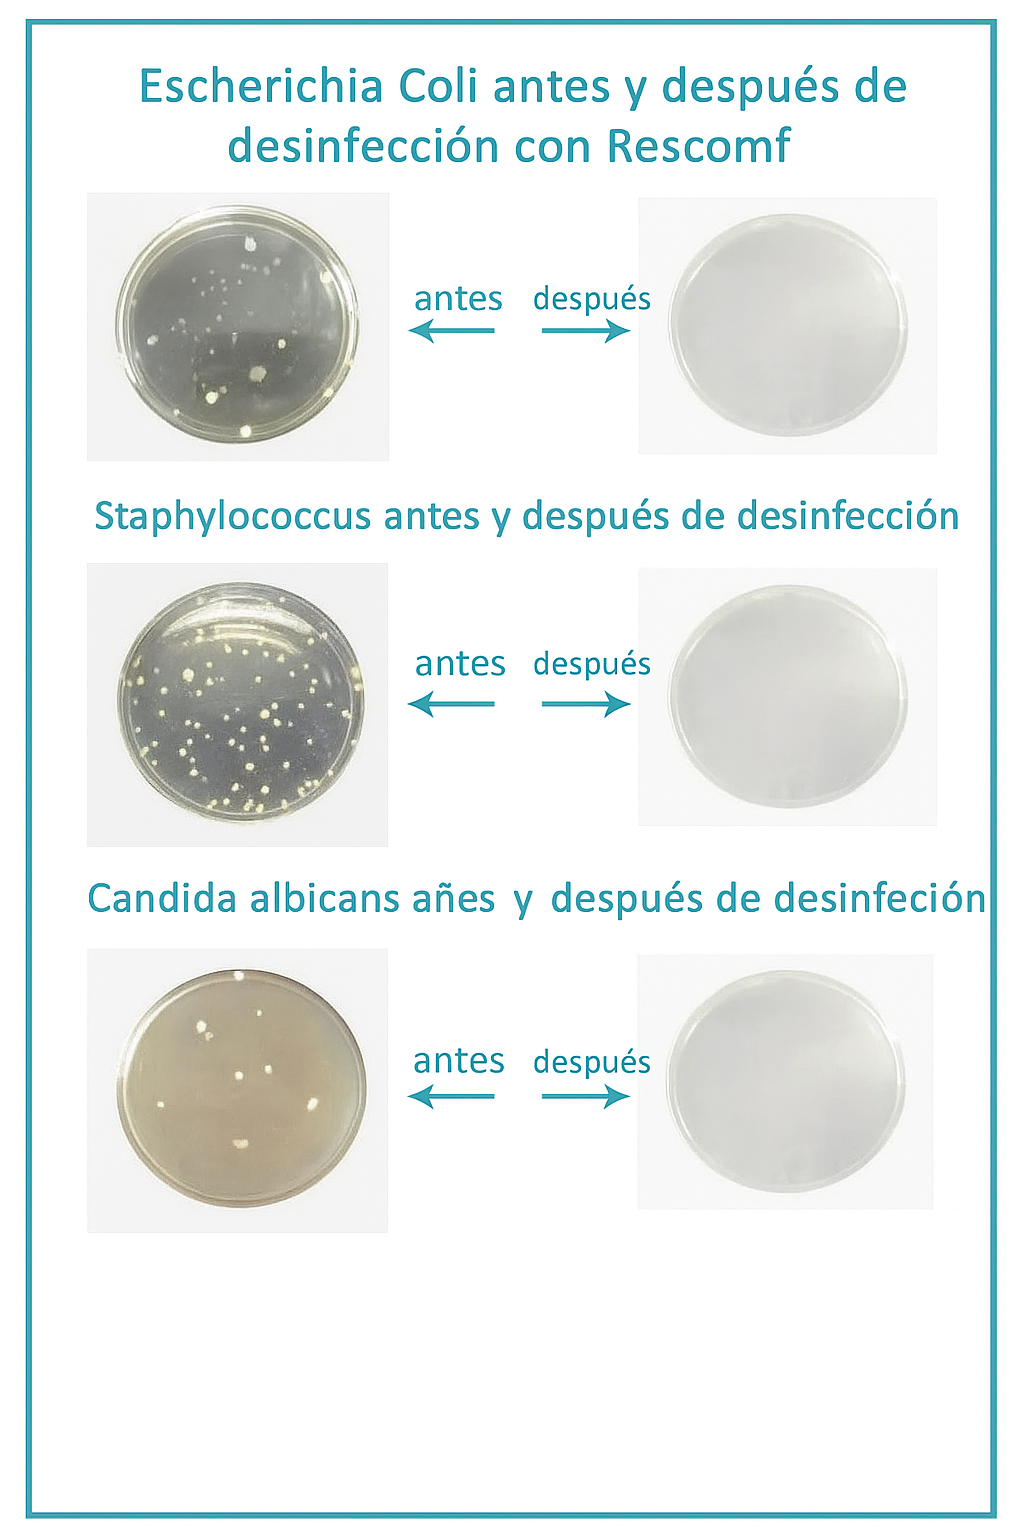

Descrizione del prodotto
Igiene Sicura e Senza Sforzo per il tuo CPAP
Mantieni il tuo apparecchio libero da batteri e muffa con questo sistema automatico di pulizia con ozono. Basta collegarlo, disinfetta il tuo CPAP in 30 minuti, senza acqua né sapone, garantendo salute e tranquillità quotidiana.

CARATTERISTICHE
✔️ Elimina il 99.99% di Germi:
Disinfezione profonda in soli 30 minuti mediante ossigeno attivato (ozono).
✔️ Uso Totalmente Automatico:
Basta collegare, accendere e lasciare che il dispositivo faccia il lavoro.
✔️ Batteria a Lunga Durata:
Ricaricabile con porta USB, offre fino a 7 cicli per carica e vita utile di 10 anni.
✔️ Compatto, Silenzioso e Portatile:
Con solo 8 once, è ideale per la casa o i viaggi, senza rumori fastidiosi.

SPECIFICHE
Metodo di Pulizia: Ozono (ossigeno attivato)
Tempo di Pulizia: 30 minuti
Eliminazione di Germi: 99.99%
Peso: 8 once
Batteria: Ioni di litio ricaricabile (10 anni di vita utile)
Tempo di Carica: 2 ore
Richiede Acqua/Sapone: No
CONTENUTO DEL PACCHETTO
1x Macchina Pulitrice e Disinfettante per CPAP
1x Cavo di Ricarica USB
Opinioni
Spedizioni e resi
CONSEGNA
- Spedizione: entro 1 a 3 giorni
- Spedizione gratuita per tutti i prodotti
- Tempi di consegna internazionale: da 7 a 10 giorni lavorativi
- Resi e cambi semplici entro 30 giorni.
RESI
Se non ti piace il prodotto, puoi restituirlo entro 30 giorni senza fornire spiegazioni. Sono esclusi i body, i costumi da bagno e gli articoli in saldo.
Abbiamo una politica di reso facile e senza complicazioni. Consulta la nostra sezione Spedizione e resi per ulteriori informazioni.